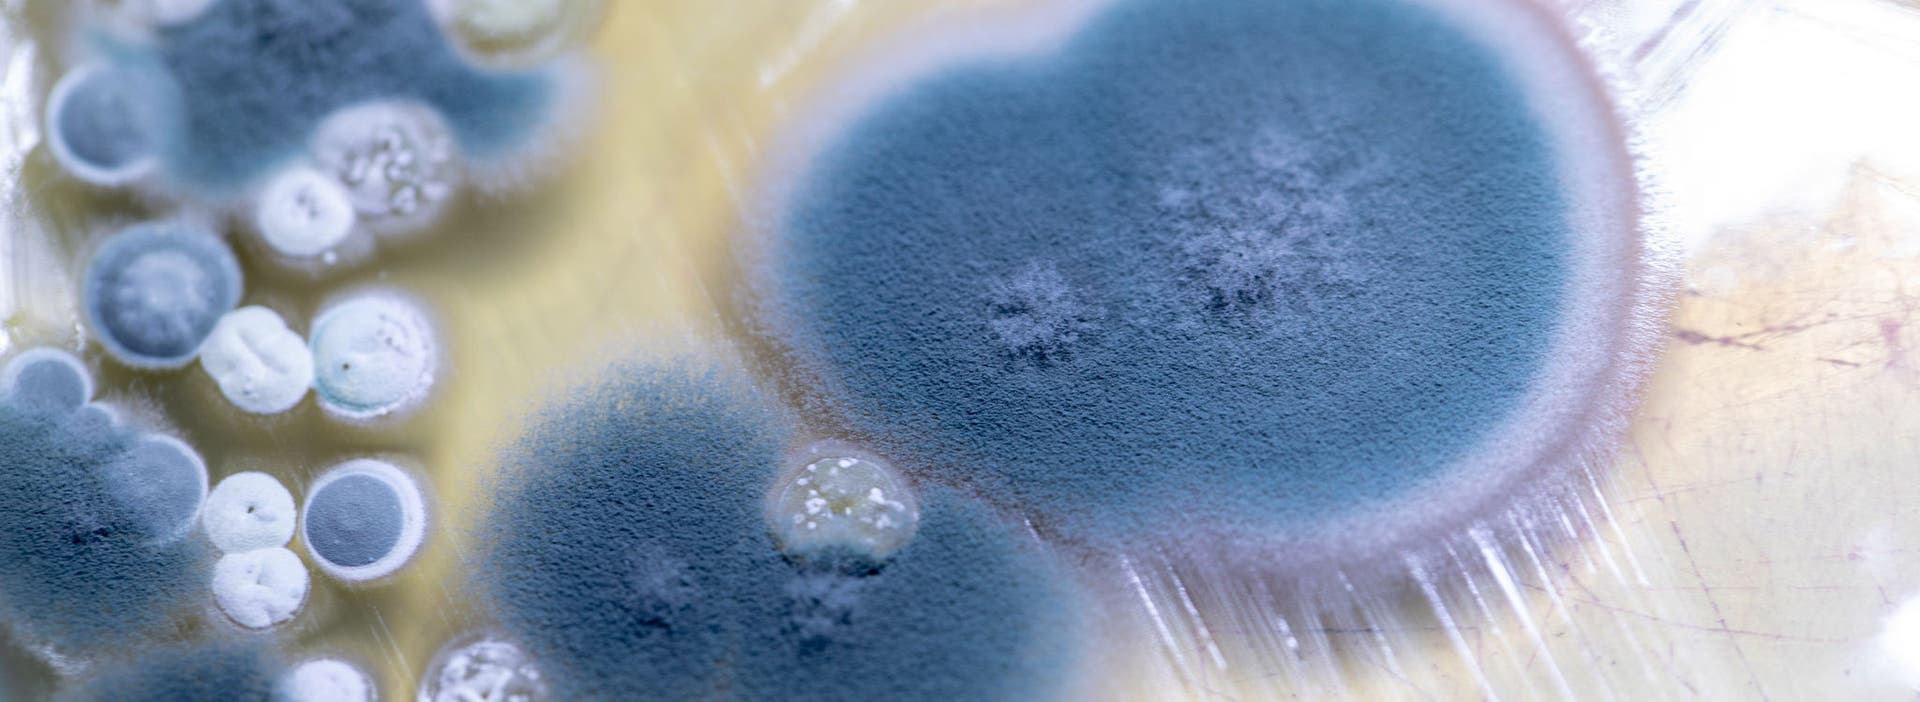

Because of warmer temperatures, humid environments, and poor storage conditions, cannabis plants and extracts (just like those from other crops) are vulnerable to mycotoxin growth. Aflatoxins (B2, G2, G1, B2, and B1) and ochratoxin A are primary types of mycotoxins that can accumulate and contaminate the end product, risking consumer safety and affecting profits.
Jumpstart your cannabis and hemp mycotoxin testing with LC-MS/MS technology
As with many hazardous contaminants, mycotoxin analysis requires instrumentation that can isolate and identify the maximum number of compounds at as low a concentration as possible. Ideally, this should all happen within a single analytical run. You need highly sensitive, specific, and selective methods for separation.
SCIEX LC-MS/MS systems provide what you need for efficient mycotoxin analysis and more. You will have high sensitivity for mycotoxin identification and quantification in cannabis samples, a workflow that includes end-to-end data acquisition, processing and support by our expert team.
To learn more about the other mycotoxin workflows that SCIEX offers, click here.
References:
- Mycotoxin regulations in 2003 and current developments. (n.d.). Retrieved October 25, 2019, from http://www.fao.org/3/y5499e/y5499e07.htm.
- KARAMICHALIS, N. (2019, July 10). Mycotoxins in Food and Feed: An Overview - Knowledge for policy European Commission. Retrieved October 25, 2019, from https://ec.europa.eu/knowledge4policy/publication/mycotoxins-food-feed-overview_en
- KARAMICHALIS, N. (2019, July 11). Regulations relating to mycotoxins in food: Perspectives a global and European context - Knowledge for policy Commission. Retrieved October 25, 2019, from https://ec.europa.eu/knowledge4policy/publication/regulations-relating-mycotoxins-food-perspectives-global-european-context_en